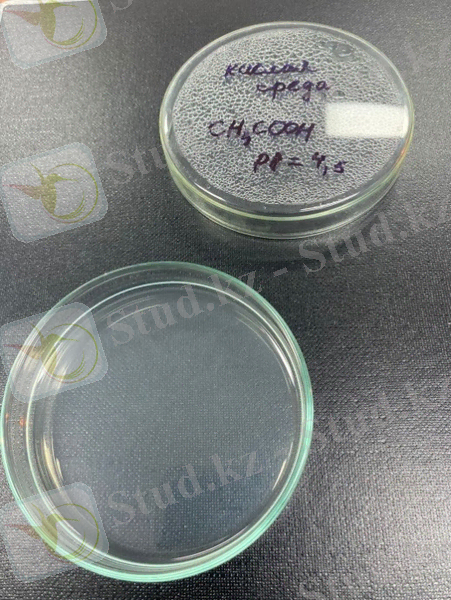

Bifidobacterium bifidum-тың физиологиялық әрекеті және зертханалық жағдайда өсіру шарттары


«Назарбаев Зияткерлік мектептері» дербес білім беру ұйымының Павлодар қаласындағы «Химия-биологиялық бағытындағы Назарбаев Зияткерлік мектебі» филиалы
ҒЫЛЫМИ-ЗЕРТТЕУ ЖҰМЫСЫ
Тақырыбы: Бифидобактериялардың физиологиялық әрекеті және оларды зертханалық жағдайда өсіру
Секция: Химия
Орындаған: 7 C сынып оқушылары
Кенжебаева Айша, Аманжол Алдияр
Ғылыми жетекшісі: химия пәнінің
мұғалімі Секен А. Е.
Павлодар қ
2022
Мазмұны
1. Кіріспе. Тақырыптың өзектілігін негіздеу3
2. Зерттеудің мақсаттары мен міндеттері 5
3. Бифидобактериялар мен олардың адам ағзасы үшін мәні 5
4. Адам үшін мәселенің өзектілігін ашу7
5. Бифидобактерия жасушаларының жіктелуі және құрылысы 9
6. Жұмыстың істәжірибелік бөлімі9
6. 1. Bifidobacterium bifidum әртүрлі орталарда өсіру 10
6. 2. Бифидобактерия бифидиумды желатинде өсіру11
6. 3. Бифидобактерия бифидиумды қоректік ортада өсіру 12
7. Жобаның іс-тәжірибелік бөліміне талдау жүргізу 13
8. Зерттеу жұмысының қорытындысы мен тұжырымдамасы 14
9. Библиографиялық тізім 15
Кіріспе
Тақырыптың өзектілігін негіздеу.
Адамның ағзасы жалғыз өмір сүрмейтіні құпия емес. Ол үшін үнемі үлкен жұмыс жасайтын көптеген көмекшілер бар. Ол үшін адам ағзасы оларды қоректендіріп, өз бойында сақтайды.
Біздің тұрақты серігіміз - бактериялар, вирустар. Олардың кейбіреулері көп көмегін, кейбіреулері аз тигізсе, ал кейбіреулері тек паразиттік өмір сүруге бейімделген. Симбиоз ағзалардың бірлесіп өмір сүруін білдіреді. Мысалы, бактериялар біздің ішектерімізде, терімізде және т. б. ағзамызда тұрақтайды.
Шартты түрде заманауи ғылым денемізде мекендейтін микроорганизмдердің бірнеше түрін ажыратады.
Бифидобактериялардың пробиотикалық әсері жұқпалы аурулардың қаупін азайтуды, физиологиялық жағдайдың әртүрлі аспектілерін жақсартуды және аллергия, астма және тіпті қатерлі ісік ауруларының даму ықтималдығын азайтуды қамтиды. Бифидобактериялардың адам ағзасындағы басым рөлі оларды медициналық биологиялық препараттардың фармакопеялық формалары үшін де, тағамдық қоспалар мен емдік және диеталық сүт биологиялық өнімдері үшін де микробтық негіз ретінде пайдалану жөніндегі зерттеулердің өзектілігін анықтайды.
- Облигатты микроағзаларішекте кездесетін және оған пайдалы әсер ететін негізгі ағзалар болып табылады. Олар баланы бірінші тамақтандырудан жерсініп және өмір бойы сақталып қалады. Адам оларды жеткілікті түрде қорыту, қоректік заттарды сіңіру, иммунитетті және жалпы асқазан-ішек денсаулығын сақтау үшін қажет.
- Шартты-патогенді микроағзалар. Бұл қосалқы маңызы бар ішектерде тұрақтайтын микроағзалар. Бұл бактериялардың тым көп болуы ауруды тудыруы мүмкін. Дені сау денеде бұл флораның өсуін «облигатты» бактериялар тежейді.
- Патогенді микроағзаларең «зиянды» болып табылады. Олар адам ағзасында тұрақталса, ауру туғызатын әсері бар. [1]
Бифидобактериялар дегеніміз не? Дененің қалыпты жұмыс істеуі үшін жағдай жасайтын микрофлора қаншалықты пайдалы? Қандай факторлар пайдалы флораның төмендеуіне және ағзаның өмірлік маңызды функцияларының бұзылуына әкеледі? Лабораторияда бифидобактерияларды өсіру мүмкін бе және қандай ортада өсіру мүмкіндігі бар?
Зерттеудің мақсаттары мен міндеттері
Зерттеу объектісі ретінде дәріхана желісіне жеткізу үшін фармакологиялық кәсіпорын ұсынған Bifidobacterium bifidum тұқымдасының облигатты микроорганизмдері, түрі - Bifidobacterium bifidum №1 және Дәріханада «Бифидумбактерин» ұнтағында сатып алынған лактозамен араласқан Bifidobacterium bifidum болып табылады.
Қолайлы жағдайда көптеген бактерияларда жасушаның бөлінуі әрбір 20-30 минут сайын жүреді. Осындай жылдам көбею кезінде бір бактерияның ұрпағы 5 күнде барлық теңіздер мен мұхиттарды толтыра алатын масса құра алады. Қарапайым есептеу бір күнде 72*10 ұрпақтың он сегізінші дәрежесіне дейін (720 000 000 000 000 000 000 жасуша) түзілуі мүмкін екенін көрсетеді. Салмаққа аударғанда - 4720 тонна болады.
Дегенмен, фармацевтика өнеркәсібіне арналған өндірісте Bifidobacterium bifidum дәріханаларда сату үшін аз мөлшерде өсіріледі.
Өндірістік міндет өсірілген бифидобактериялардың концентрациясын арттыру, сондай-ақ оны өндіру технологиясын жеңілдету болып табылады.
Зерттеудің мақсаты:
1. Bifidobacterium bifidum өсіндісін және оның адам ағзасындағы рөлін зерттеу.
2. Bifidobacterium bifidum зертханалық жағдайда өсу мүмкіндігін эмпирикалық жолмен анықтау.
3. Зертханалық жағдайда бактериялардың өну және бөлінуіне қолайлы орта мен жағдайларды анықтау.
4. Bifidobacterium bifidum үшін зертханада өзіңіздің қоректік ортаңызды жасау.
Бифидобактериялар мен олардың адам ағзасы үшін мәні
Жер бетінде бактериялар болмайтын жер табу қиын. Олар атмосферада және мұхиттардың түбінде, жылдам ағып жатқан өзендерде және мәңгі мұзда, жаңа сүтте және ядролық реакторлар сияқты алуан түрлі жерлерде кездеседі, әсіресе олар топырақта көптеп кездеседі. Топырақтың үстіңгі қабатындағы 1 граммға есептегенде миллиондаған бактериялар сәйкес келеді, бұл шамамен гектарына 2 тоннаны құрайды. Адамдарда, өсімдіктерде және жануарларда паразиттік тіршілік ететін бактериялардың көптеген түрлері бар.
Бифидобактериялар - адамның қалыпты микрофлорасының негізгі өкілдерінің бірі. Bifidobacterium тұқымдасының 20-дан астам түрі бар. Типтік түрі - Bifidobacterium bifidum. Бифидобактериялардың аш және тоқ ішек негізгі тіршілік ету ортасы болып табылады.
* Бифидобактериялар ағзаны патогенді микрофлорадан қорғайды және шартты микроорганизмдердің өсуін тежейді, әсіресе өмірдің бірінші жылындағы балаларда. Олар В дәрумендерін шығарады және иммуностимуляциялық әсерге ие. Қалыпты микрофлорадағы бифидобактериялар санының төмендеуі ас қорыту бұзылыстарымен бірге жүретін дисбиоздың маңызды көрсеткіші болып табылады.
* Бифидобактериялар қалыпты ішек микрофлорасының басқа мүшелерімен бірге көптеген дене функцияларын орындайды немесе реттейді. Өмірлік белсенділік процесінде олар органикалық қышқылдарды түзеді, бұл ішек үшін қалыпты ортаны құруға әкеледі, патогендік, шірік және газ түзетін ішек микрофлорасының көбеюіне жол бермейді.
*Бифидобактериялар айқын микробтық антагонизмге ие, қалыпты ішек флорасының белгілі бір сандық және сапалық құрамын реттейді, ішекте патогенді және шартты микробтардың өсуі мен көбеюін тежейді, бұл организмді қорғаудың, әсіресе ерте жаста, ішек инфекцияларының дамуынан бастап, маңызды фактісі болып табылады
*Қалыпты ішек флорасының басқа өкілдерімен қатар бифидобактериялар ас қорытуға және сіңіруге белсенді қатысады. Олар тағамның ферментативті қорытылуына ықпал етеді, өйткені олар ақуыздардың гидролизін күшейтеді, көмірсуларды ашытады, майларды сабындатады, талшықты ерітеді, ішек моторикасын ынталандырады және ішектің қалпына келуін ықпал етеді.
* Бифидобактериялар дәрумендік қызметін атқарады. Олар В тобындағы витаминдердің, К витаминінің, фолий мен ниациннің синтезі мен сіңуіне қатысады, алмастырылмайтын амин қышқылдарының синтезіне ықпал етеді, кальций тұздарын, D витаминін жақсы сіңіреді, анемияға қарсы, антирахиттік және антиаллергиялық әсерге ие. [2]
Зерттеу тарихы
1676 жылы алғаш рет бактерияларды оптикалық микроскоп арқылы көріп, оны зерттеген голландтық табиғат зерттеушісі Энтони ван Левенгук болды. Барлық микроскопиялық тіршілік иелері сияқты ол оларды «анималькули» деп атады.
1828 жылы Кристиан Эренберг «Бактериялар» атауын енгізген.
1850 жылдары Луи Пастер бактериялардың физиологиясы мен метаболизмін зерттеуге кірісті, сонымен қатар олардың ауру тудыратын қасиеттерін ашты. Медициналық микробиология Роберт Кохтың еңбектерінде одан әрі дамытып, ол аурудың қоздырғышын анықтаудың жалпы принциптерін тұжырымдады (Кох постулаттары) . 1905 жылы туберкулезді зерттегені үшін Нобель сыйлығының лауреаты атанды. [3]
Адам үшін мәселенің өзектілігін ашу
Қазақстан Медицина ғылымдары академиясының мәліметтері бойынша, Қазақстан халқының 90% дерлік дисбактериоздан зардап шегеді. Дисбактериозға әкелетін себептердің бірнеше топтары бар: әртүрлі соматикалық жұқпалы аурулар; антибиотиктерді қабылдау; химиотерапия, гормондық терапия және сәулелік терапия; стресстік жағдайлар; үлкен физикалық белсенділік және шамадан тыс жұмыс; қолайсыз экологиялық жағдай; әлеуметтік факторлар (дәрумендердің жетіспеушілігі, теңгерімсіз тамақтану), шамадан тыс тамақтану (бір уақытта көп мөлшерде тағамды тұтыну, асқазан қабырғаларының созылуын тудыратын және тағам қоспасының ашытуының бұзылуы) ; алкоголизм; маусымдық факторлар (күз және көктем) ; жасы. Қазіргі ресейлік жағдайлар үшін жоғарыда аталған себептердің толық жиынтығы тән, олар жедел және созылмалы дисбиозды тудырады.
Дисбактериоз - «пайдалы» және «патогенді» зиянды микрофлораның саны мен сапасы арасындағы теңгерімсіздік. Бұл жағдайдың көптеген себептері бар. Әдетте, бірнеше факторларды біріктіретін жағдайлар пациенттерді алаңдататын белгілердің басталуымен ауыр ауруға әкеледі. Экология қоршаған орта факторларынан күрт ерекшеленеді. Бұл зауыттар мен фабрикалардан зиянды шығарындылары бар ауа, тамақтағы ауыр металдар, радиация және т. б.
Сыртқы жағдайларға, атап айтқанда, өндірістік қауіптер мен өмір сүру жағдайлары жатады.
Флораның қысқа мерзімді өзгеруі байқалмай қалуы мүмкін, бірақ бифидобактериялар колонияларының ұзақ немесе айтарлықтай төмендеуімен бұл жағымсыз көріністерге әкеледі.
Антибиотиктердің әрекеті маңызды рөл атқарады. Бір жағынан, антибиотикалық терапия агрессивті патогендік микрофлораны өлтіру арқылы жақсы нәтижеге жеткізеді. Бірақ екінші жағынан, олар «пайдалы флораның» басылуына да себепші болатынын ұмытпаған жөн.
Дисбактериоз кезінде ас қорыту процестерінің бұзылуы май, көмірсу, ақуыз, су-тұз, витамин алмасуы сияқты метаболикалық бұзылуларға әкеледі. Метаболикалық бұзылулардың белгілеріне салмақ жоғалту, өт қышқылдарының секрециясының болмауы, майда еритін витаминдердің жетіспеушілігі (тері құрғақтығы, бұлыңғыр көру) жатады.
Бұл денедегі май қыртыстарынан арылғысы келетін адамдар бұл мәселеде май алмасуын бұзатын дисбиозға байланысты сәтсіздікке ұшырауы мүмкін дегенді білдіреді. Дисбиоз кезінде кальций сіңуінің белсенді төмендеуі орын алады, бұл остеопорозға әкеледі (сүйектердің сынғыштығы, саусақтардың және саусақтардың ұюы, конвульсиялар) . Көріп отырғаныңыздай, дисбактериоз асимптоматикалық курстан айқын көрсетілген ауыр клиникалық формаларға дейін көрініс табады. Дисбактериозды емдеу оңай емес. Дегенмен, адам-қоршаған ортаның экожүйесіндегі қалыпты тепе-теңдікті қалпына келтіру және микрофлораны арнайы бифидті өнімдермен түзету дәстүрлі терапияға жауап беру қиын бірқатар ауруларда денсаулықты айтарлықтай жақсартуға әкелуі мүмкін. [4]
Әлемнің ірі индустриалды елдерінде және, атап айтқанда, Ресейде дисбиозды жаппай анықтау адамзатты қалпына келтіретін бактериялық терапия үшін сенімді құралдардың арсеналын іздеуге мәжбүр етті. Бифидобактериялар ішек микрофлорасының негізгі бөлігін құрайтынын ескере отырып, құрамында бифидобактериялары бар препараттармен - эубиотиктермен, сондай-ақ функционалдық тамақтану деп аталатын категорияға жататын бифидобактериялары бар тағамдар мен сусындармен терапия олардың тапшылығын түзету әдісі болды. [5]
Бифидобактерия жасушаларының жіктелуі және құрылысы
Bifidobacterium bifidum №1 Bifidobacterium тұқымдасына жатады. Bifidobakterium туысының бактериялары, Бергейдің Бактерияларға нұсқаулығына (1997) сәйкес Procaryotae патшалығының Firmicutes бөлімшесінің Thallobacteria класының 20 бөлігінің Actinomycetaceae тұқымдасына жатады.
Морфологиялық белгілері бойынша Bifidobasterium тұқымдас бифидобактерияларының жасушалары спора түзбейтін, грамон таяқшалар, көлемі 0, 5-1, 3×1, 5-8 мкм болады. Жасушалардың пішіні түзу шыбықтардан кесек тәрізді, соңында клаватты қалыңдалған, кейде тармақталған (В-, Т-формалары), түйіршікті; таза дақылдарда олар полиморфты болып кездеседі.
Жасушалардың орналасуы бір, жұп, кейде шынжыр немесе розетка түрінде болып табылады. Кейде ісінген жасушалар түрінде кездеседі. Анаэробтар. Кейбір түрлер 10% СО2-мен байытылған ауада өсе алады.
Бактериялар - цитоплазмасында түзілген ядросы жоқ қарабайыр бір клеткалы организмдер. Ядролық зат бүкіл цитоплазмада таралған. [6]
Жұмыстың іс-тәжірибелік бөлімі
Зерттеу объектісі ретінде:
- Дәріханада «Бифидумбактерин» ұнтағында сатып алынған лактозамен араласқан Bifidobacterium bifidum.
Түрлі рН мәндері бар тұзды ерітіндіде Bifidobacterium bifidum өсіру
Бифидобактериялар үшін бейтарап ортаға артықшылық беріледі, бірақ pH=3 болатын асқазаннан өткен кезде олар қышқыл шокқа ұшырайды және ішінара белсенділігін жоғалтады. Айта кету керек, бифидобактериялардың қышқыл стресске бейімделуіне қатысты мәселелер аз зерттелген.
Осыған байланысты қосымша зерттеулер бифидобактериялардың рН төмен мәндеріне тұрақтылығын зерттеуге арналды. Ол үшін модельдік тәжірибелер жүргізілді. Нәтижелер эксперимент барысында көрсетілген.
Бифидобактерияларға өсуіне қолайлы ортаны анықтау үшін түрлі ортаны көрсететін ерітінділер дайындадық:
а) бейтарап ортада;
б) қышқыл ортада;
в) сілтілі ортада .
Тұзды - қан плазмасына тән сулы ерітінді. Бұл түрдегі ең қарапайым ерітінді натрий хлоридінің (NaCl) 0, 9% сулы ерітіндісі болып табылады. Біз зертханада осы ерітіндіні дайындадық. Бұл бізде бейтарап орта болды.
рН=4, 5 қышқылдық орта құру үшін сірке қышқылы қосылды (қышқылдың мөлшері индикаторлық қағаздың түсін өзгерту арқылы және Ph-метр құралы арқылы анықталды) .
рН 7, 4 сілтілік орта жасау үшін ас содасы қосылды. Оның мөлшері де дәл осылай анықталды.
Бифидобактерияларды өсіру кептіру шкафында 3 тәулік бойы жүргізілді.
Іс-тәжірибе бөлімінің нәтижелері:
Бактериялар бифидумбактерин ұнтағынан рН = 7, 4 сілтілі ортада жақсы өнген;
• рН = 7, 0 бейтарап ортада нашар өскен;
• Қышқыл ортада толық өнбеген (кейіннен саңырауқұлақтар осы субстратқа қоныстанған) .
Бақылау визуалды түрде жүргізілді. Сандық есептеулер жүргізілмеді. Сұйық қоректік орталарда өсу біркелкі лайлану немесе біртекті немесе азырақ түйіршікті шөгіндінің тұнбасы түрінде байқалады.

А В С
Сурет 1. Түрлі рН мәндері бар тұзды ерітіндіде Bifidobacterium bifidum өсіру
А) Қышқылдық орта, ph=4, 5
В) Бейтарап орта, ph=7
С) Сілтілік орта, ph=7, 4
Қорытынды: Bifidobacterium bifidum бактерияларының өсуі мен көбеюі үшін сілтілі орта қажет.
Bifidobacterium bifidum желатинде өсіру
Желатин нұсқауларға сәйкес тұзды ерітіндімен сұйылтылған, ісінуден кейін ол қайнатылған және Петри табақшасына құйылған.
... жалғасы- Іс жүргізу
- Автоматтандыру, Техника
- Алғашқы әскери дайындық
- Астрономия
- Ауыл шаруашылығы
- Банк ісі
- Бизнесті бағалау
- Биология
- Бухгалтерлік іс
- Валеология
- Ветеринария
- География
- Геология, Геофизика, Геодезия
- Дін
- Ет, сүт, шарап өнімдері
- Жалпы тарих
- Жер кадастрі, Жылжымайтын мүлік
- Журналистика
- Информатика
- Кеден ісі
- Маркетинг
- Математика, Геометрия
- Медицина
- Мемлекеттік басқару
- Менеджмент
- Мұнай, Газ
- Мұрағат ісі
- Мәдениеттану
- ОБЖ (Основы безопасности жизнедеятельности)
- Педагогика
- Полиграфия
- Психология
- Салық
- Саясаттану
- Сақтандыру
- Сертификаттау, стандарттау
- Социология, Демография
- Спорт
- Статистика
- Тілтану, Филология
- Тарихи тұлғалар
- Тау-кен ісі
- Транспорт
- Туризм
- Физика
- Философия
- Халықаралық қатынастар
- Химия
- Экология, Қоршаған ортаны қорғау
- Экономика
- Экономикалық география
- Электротехника
- Қазақстан тарихы
- Қаржы
- Құрылыс
- Құқық, Криминалистика
- Әдебиет
- Өнер, музыка
- Өнеркәсіп, Өндіріс
Қазақ тілінде жазылған рефераттар, курстық жұмыстар, дипломдық жұмыстар бойынша біздің қор #1 болып табылады.



Ақпарат
Қосымша
Email: info@stud.kz